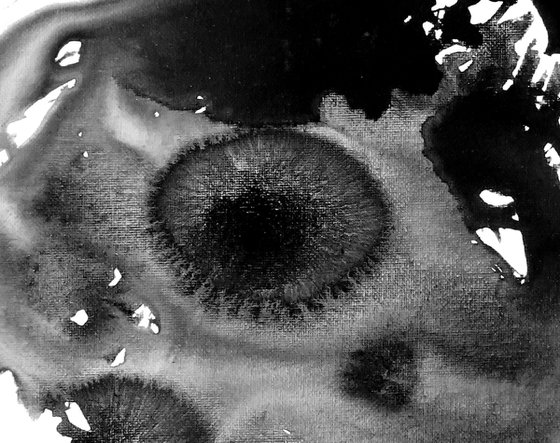

- Newel Hunter
- All Artworks
- Ocular
Ocular (2025) Original Acrylic Painting by Newel Hunter
40.64 x 50.8 x 0.51cm (unframed)
£1,220.18
Original artwork description
“Ocular” features a monochromatic abstract composition centered on a loose, organic form resembling an eye rendered in watery black acrylic paint. The shape has fluid edges that spread unevenly across the white background, creating a sense of movement and vitality. Within the central mass, varying densities of black ink create areas of depth and texture, with some parts forming soft, circular patterns that add a subtle layer of complexity. Smaller splatters and droplets surround the main form, enhancing the dynamic, organic and spontaneous feeling of the piece. The contrast between the dark paint and the pristine white space emphasizes the interplay of form and void, inviting the viewer to explore the tactile quality and rhythm of the painting’s flow. Here’s looking at you.
Ocular is painted with acrylic on a16 x 20 inch canvas panel, ready to frame. It comes carefully packaged and shipped in a heavy-duty cardboard box. Accompanied by a signed Certificate of Authenticity.
Materials used:
Acrylic on canvas panel
Details:
- Acrylic painting on Canvas
- One of a kind artwork
- Size: 40.64 x 50.8 x 0.51cm (unframed)
- Signed on the back
- Style: Expressive and gestural
- Subject: Abstract and non-figurative
14 day money back guaranteeLearn more
Original artwork description
“Ocular” features a monochromatic abstract composition centered on a loose, organic form resembling an eye rendered in watery black acrylic paint. The shape has fluid edges that spread unevenly across the white background, creating a sense of movement and vitality. Within the central mass, varying densities of black ink create areas of depth and texture, with some parts forming soft, circular patterns that add a subtle layer of complexity. Smaller splatters and droplets surround the main form, enhancing the dynamic, organic and spontaneous feeling of the piece. The contrast between the dark paint and the pristine white space emphasizes the interplay of form and void, inviting the viewer to explore the tactile quality and rhythm of the painting’s flow. Here’s looking at you.
Ocular is painted with acrylic on a16 x 20 inch canvas panel, ready to frame. It comes carefully packaged and shipped in a heavy-duty cardboard box. Accompanied by a signed Certificate of Authenticity.
Materials used:
Acrylic on canvas panel
Details:
- Acrylic painting on Canvas
- One of a kind artwork
- Size: 40.64 x 50.8 x 0.51cm (unframed)
- Signed on the back
- Style: Expressive and gestural
- Subject: Abstract and non-figurative